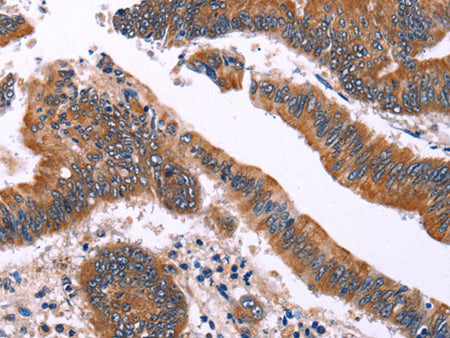
IRAK1BP1 Polyclonal Antibody Store at -20°C

IRAK1BP1 Polyclonal Antibody Store at -20°C
Couldn't load pickup availability

Still have questions? Ask our experts!
IRAK1BP1 Polyclonal Antibody Store at -20°C
| SKU # | E-AB-10411 |
| Reactivity | Human, Mouse |
| Host | Rabbit |
| Applications | WB, IHC |
Product Details
| Isotype | IgG |
| Host | Rabbit |
| Reactivity | Human, Mouse |
| Applications | WB, IHC |
| Clonality | Polyclonal |
| Immunogen | Recombinant protein of human IRAK1BP1 |
| Abbre | IRAK1BP1 |
| Synonyms | AIP70, ActA binding protein 3, IRAK1-binding protein 1, Interleukin 1 receptor associated kinase 1 binding protein 1, SIMPL, Signaling molecule that associates with Pelle-like kinase |
| Swissprot | |
| Calculated MW | 29 kDa |
| Cellular Localization | Cytoplasmic and Nuclear. |
| Concentration | 0.4 mg/mL |
| Buffer | Phosphate buffered solution, pH 7.4, containing 0.05% stabilizer and 50% glycerol. |
| Purification Method | Affinity purification |
| Research Areas | Immunology, Signal Transduction |
| Conjugation | Unconjugated |
| Storage | Store at -20°C Valid for 12 months. Avoid freeze / thaw cycles. |
| Shipping | The product is shipped with ice pack,upon receipt,store it immediately at the temperature recommended. |
Related Reagents
| Applications | Recommended Dilution |
| WB | 1:500-1:2000 |
| IHC | 1:50-1:200 |
Background
SIMPL, also known as IRAK1BP1 (interleukin-1 receptor-associated kinase 1-binding protein 1), is a 260 amino acid protein belonging to the IRAK1BP1 family. In addition to containing an intrinsically disordered region which associates with HSPA1 and HSPA8, SIMPL also interacts directly with IRAK1 and promotes RELA transcriptional activity. SIMPL is a major component of the IRAK1-dependent TNFRSF1A signaling pathway in which TNF-alpha induces NF-kappa-B gene transcription, leading to an inhibition of proinflammatory cytokines. Inactivation of SIMPL inhibits tumor necrosis factor receptor type I-induced NF-kappaB activity. Localizing to the nucleus and cytoplasm, SIMPL requires the phosphorylation of Ser-56 and/or Ser-62 to be fully active.
.